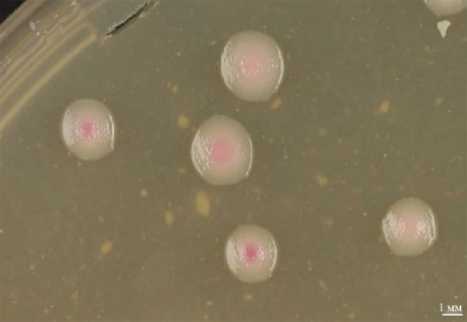

Биологические особенности и методы идентификации Erwinia rhapontici (Millard 1924) Burkholder 1948 (обзор)
Автор: Авдеев И.С., Панченко К.В., Словарева О.Ю.
Журнал: Сельскохозяйственная биология @agrobiology
Рубрика: Обзоры, проблемы
Статья в выпуске: 1 т.61, 2026 года.
Бесплатный доступ
Фитопатогенная бактерия Erwiniarhapontici(=Pectobacteriumrhapontici) вызывает бактериозы ряда сельскохозяйственных культур и причиняет существенный экономический ущерб в местах своего распространения (H.C. Huang с соавт., 2003). В России E. rhapontici как фитопатоген практически не изучалась, и известно всего о четырех случаях ее обнаружения (R.I. Gvozdyak с соавт., 1987; А.М. Лазарев с соавт., 2020; А.С. Дымнич с соавт., 2022; Словарева с соавт., 2025). Обострение эпифитотической обстановки с участием E. rhapontici (M.J. Jeger с соавт., 2023), а также необходимость обеспечить отсутствие патогена в зерновой продукции, экспортируемой из России в Китай, Судан и другие страны, обусловливают актуальность сбора и анализа сведений о биологических особенностях и методах идентификации E. rhapontici. Впервые фитопатоген обнаружен в 1924 году в Англии. С тех пор номенклатура бактерии многократно менялась, и в настоящее время полным утвержденным названием является Erwinia rhapontici (Millard 1924) Burkholder 1948 (G.M. Garrity с соавт., 2007). Ареал фитопатогена расположен в ряде стран Америки, Азии, Европы и Океании. Бактерия вызывает розовый бактериоз зерна у зерновых и зернобобовых культур, а также мягкую гниль и другие симптомы у растений из ботанических семейств Actinidiaceae, Araceae, Amaranthaceae, Amaryllidaceae, Apiaceae, Asparagaceae, Asteraceae, Brassicaceae, Caryophyl-laceae, Ericaceae, Fabaceae, Lamiaceae, Moraceae, Poaceae, Polygonaceae, Primulaceae, Orchidaceae, Rosaceae, Rutaceae, Solanaceae. Источником заражения служат семена, растительные остатки и почва (H.C. Huang с соавт., 2003). Определяющим условием развития бактериоза становятся механические повреждения растений (J.E. Sellwood с соавт., 1978). Бактерия палочковидная, грамотрицательная, факультативно анаэробная, подвижная, имеет несколько перитрихиальных жгутиков (Y. Hashidoko с соавт., 2002). E. rhapontici способна к ферментации широкого ряда углеводов, но главная особенность, отличающая ее от большинства других видов, — способность к ферментации изомальтулозы и ее биоконверсии из сахарозы (A.J. Sardiña-Peña с соавт., 2023). Бактерия демонстрирует чувствительность к некоторым противомикробным веществам, таким как эритромицин, стрептомицин, неомицин, меропенем, энрофлоксацин, цефоперазону, цефтазидиму, ципрофлоксацин, гентамицин, масло орегано и соединения, вырабатываемые Bacillus velezensis (H.C. Huang с соавт., 2003; И.С. Авдеев с соавт., 2025; M.J. Simirgiotis с соавт., 2020; J. Wilson с соавт., 2023). Обнаружение E. rhapontici в растительном и семенном материале проводится с применением методов предварительной подготовки проб, которые заключаются в поверхностной стерилизации образцов и приготовлении смывов или экстракции, иногда с последующим центрифугированием с целью повышения концентрации бактериальных клеток в пробе (D. Wang с соавт., 2017). Культура фитопатогена выделяется на средах общего назначения. Идентификацию культур проводят биохимическими, молекулярно-генетическими и масс-спектрометрическими методами. Для биохимической идентификации используют классические методы, такие как «пестрый ряд» Гисса, и коммерческие тест-системы (Р.Р. Салихов с соавт., 2021; K.A. Wise с соавт., 2008). В мировой практике широко используется ПЦР-амплификация различных участков генома E. rhapontici с последующим секвенированием (A.O. Adesemoye с соавт., 2016; J. Wang с соавт., 2022; О.Ю. Словарева с соавт., 2025). Существует несколько видоспецифичных ПЦР-тестов, мишенью которых служат различные нуклеотидные последовательности, уникальные для E. rhapontici(M. Tsuji с соавт., 2020; S.P. Thapa с соавт., 2012; I. Gehring, K. Geider, 2012; T. Naas с соавт., 2004). Для идентификации E. rhapontici с высокой степенью достоверности может быть использован метод времяпролетной масс-спектрометрии с лазерной десорбцией-ионизацией при содействии матрицы (MALDI-TOF MS) (T. Kovacs с соавт., 2020). Собранные сведения о биологических свойствах и существующих методах идентификации E. rhaponticiмогут быть использованы при разработке диагностических методик и определении перспективных направлений для дальнейшего изучения этого фитопатогена.
Бактериозы зерновых культур, корончатая гниль, идентификация фитопатогенов, розовый бактериоз зерна пшеницы и ржи, MALDI-TOF, ПЦР, защита и карантин растений
Короткий адрес: https://sciup.org/142247329
IDR: 142247329 | УДК: 632.3.01/.08^579.64: | DOI: 10.15389/agrobiology.2026.1.40rus
Biological features and identification methods of Erwinia rhapontici (Millard 1924) Burkholder 1948 (review)
The phytopathogenic bacterium Erwinia rhapontici (=Pectobacterium rhapontici) causes bacteriosis in a number of crops and causes significant economic damage in its distribution areas (H.C. Huang et al., 2003). In Russia, E. rhapontici as a phytopathogen has been poorly studied, and only four cases of its detection are known (R.I. Gvozdyak et al., 1987; A.M. Lazarev et al., 2020; A.S. Dymnich, E.V. Glinskaya, 2022; O.Yu. Slovareva et al. 2025). Exacerbation of the epiphytotic situation involving E. rhapontici (M.J. Jeger et al., 2023), as well as the need to ensure the absence of a pathogen in exported from Russia to China, Sudan, etc. grain products, determine the relevance of collecting and analyzing information on the biological features and identification methods of E. rhapontici. The phytopathogen was first discovered in 1924 in England. Since then, the nomenclature of the bacterium has changed many times, and currently the full approved name is Erwinia rhapontici (Millard 1924) Burkholder 1948 (G.M. Garrity et al., 2007). The range of the phytopathogen is located in a number of countries in America, Asia, Europe and Oceania. The bacterium causes pink grain bacteriosis in cereals and legumes, as well as mild rot and other symptoms in a wide range of plants from such botanical families as Actinidiaceae, Araceae, Amaranthaceae, Amaryllidaceae, Apiaceae, Asparagaceae, Asteraceae, Brassicaceae, Caryophyllaceae, Ericaceae, Fabaceae, Lamiaceae, Moraceae, Poaceae, Polygonaceae, Primulaceae, Orchidaceae, Rosaceae, Rutaceae, Solanaceae. The source of infection is seeds, plant residues and soil (H.C. Huang, R.S. Erickson, 2003). The determining condition for the development of bacteriosis is mechanical damage to plants (J.E. Sellwood, R.A. Lelliott, 1978). The bacterium is rod-shaped, gram-negative, facultatively anaerobic, motile, and has several peritrichial flagella (Y. Hashidoko et al., 2002). E. rhapontici is capable of fermenting a wide range of carbohydrates, but the main feature that distinguishes it from most other species is its ability to ferment isomaltulose and its bioconversion from sucrose (A.J. Sardiña-Peña et al., 2023). The bacterium demonstrates sensitivity to certain antimicrobial substances, such as erythromycin, streptomycin, neomycin, meropenem, enrofloxacin, cefoperazone, ceftazidime, ciprofloxacin, gentamicin, oregano oil and compounds produced by Bacillus velezensis (H.C. Huang et al., 2003; I.S. Avdeev et al. 2025; M.J. Simirgiotis et al., 2020; J. Wilson et al., 2023). Detection of E. rhapontici in plant and seed material is carried out using pre-sample preparation methods, which consist in surface sterilization of samples and preparation of flushes or extraction, sometimes followed by centrifugation in order to increase the concentration of bacterial cells in the sample (D. Wang et al., 2017). The culture of the phytopathogen is isolated on general purpose media. The isolated cultures are identified by biochemical, molecular genetic, and mass spectrometric methods. Classical methods such as Hiss's "Color Row" and commercial test systems are used for biochemical identification (R.R. Salikhov et al., 2021; K.A. Wise et al., 2008). PCR amplification of various regions of the E. rhapontici genome, followed by sequencing, is widely used worldwide (A.O. Adesemoye et al., 2016; J. Wang et al., 2022; O.Yu. Slovareva et al. 2025). There are several species-specific PCR assays that target different nucleotide sequences unique to E. rhapontici (M. Tsuji et al., 2020; S.P. Thapa et al., 2012; I. Gehring, K. Geider, 2012; T. Naas et al., 2004). Time-of-flight mass spectrometry with laser desorption-ionization assisted by a matrix (MALDI-TOF MS) can be used to identify E. rhapontici with a high degree of reliability (T. Kovacs et al., 2020). The collected information on the biological properties and existing methods of identification of E. rhapontici can be used in the development of diagnostic techniques and identification of promising areas for further study of this phytopathogen.
Текст научной статьи Биологические особенности и методы идентификации Erwinia rhapontici (Millard 1924) Burkholder 1948 (обзор)
Болезни бактериальной этиологии — одна из причин снижения урожая сельскохозяйственных культур во всем мире (1), при этом виды бактерий рода Erwinia вирулентны в отношении многих экономически значимых растений (2). Например, E. amylovora вызывает опасное заболевание — бактериальный ожог плодовых культур, наносящее массовое поражение яблоневым садам и дикорастущим яблоням (3-5). К другим фитопатогенным представителям рода относятся E. pyrifoliae Kim et al. 1999 (6, 7), E. persicina Hao et al. 1990 (8, 9), E. pyri He et al. 2024 (10), E. aphidicola Harada et al. 1998 (11) E. mallotivora Goto 1976 (12), E. tracheiphila (Smith 1895) Bergey et al. 1923 (13, 14) и прочие.
Особенно следует заострить внимание на E. rhapontici , вызывающей существенные потери урожая и снижение качества растительной продукции зерновых (15, 16), зернобобовых (17, 18), плодовых (19, 20), овощных (21, 22), декоративных культур (23) и древесных растений (24). Интерес к указанному виду вызван ухудшением эпифитотической обстановки с его участием (1), а также фитосанитарным регулированием E. rhapontici импортерами российского зерна пшеницы (25). Бактерия имеет статус карантинного организма для как минимум 17 стран, включая Китай, Судан и Южно-Африканскую Республику (табл. 1).
1. Фитосанитарный статус Erwinia rhapontici в разных странах
|
Страна |
Статус |
Ссылка |
|
Бразилия |
Отсутствующий карантинный вредный организм |
(26) |
|
Буркина-Фасо |
Отсутствующий карантинный организм, контролируется в отношении Allium sp. |
(27) |
|
Гватемала |
Регулируемый карантинный объект |
(28) |
|
Гвинея-Бисау |
Присутствующий карантинный организм, контролируется в отношении Allium sp. |
(29) |
|
Венесуэла |
Карантинный вредитель |
(30) |
|
Индонезия |
Карантинный объект, контролируется в отношении большого перечня сельхоз продукции, в том числе в отношении зерна пшеницы |
(31) |
|
Китай |
Вредный организм, который недопустим к ввозу, если не существует надежной карантинной обработки для его обезвреживания |
(32) |
|
Колумбия |
Регулируемый присутствующий вредный организм |
(33) |
|
Коста-Рика |
Отсутствующий карантинный вредный организм, контролируется в отношении к Allium cepa , Allium spp. |
(34) |
|
Мали |
Карантинный вредный организм, контролируется в отношении пшеницы |
(35) |
|
Никарагуа |
Отсутствующий регулируемый вредный организм, контролируется в отношении зерна пшеницы |
(36) |
|
Судан |
Карантинный вредный организм, контролируется в отношении зерна пше- |
|
|
ницы |
(37) |
|
|
Тайвань (Китай) |
Вредный организм, который недопустим к ввозу, если не существует надежной карантинной обработки для его обезвреживания |
(38) |
|
Того |
Карантинный организм |
(39) |
|
Шри-Ланка |
Регулируемый вредный организм |
(40) |
|
Эквадор |
Отсутствующий карантинный вредный организм |
(41) |
|
ЮАР |
Регулируемый организм |
(42) |
Объем экспорта зерна пшеницы в вышеперечисленные страны составил в 2024 году около 5,1 млн т и в 2025 году около 2,2 млн т (43).
Обеспечение фитосанитарного мониторинга участков производства, а также оценка соответствия зерновой продукции фитосанитарным требованиям стран-импортеров требует наличия диагностических методик, которые на сегодняшний день отсутствуют для E. rhapontici.
В настоящем обзоре рассмотрены сведения о биологических особенностях и методах идентификации Erwinia rhapontici .
Номенклатура и систематика. Впервые патоген был выделен в 1924 году в Англии из растения ревеня (Rheum rhaponticum L.) с симпто- мами вершинной гнили (crown rot) (44). Сведения, представленные в таблице 2, демонстрируют историю изменений номенклатуры бактерии.
Полное принятое научное название бактерии — Erwinia rhapontici (Millard 1924) Burkholder 1948, что отражено в таксономическом очерке бактерий и архей (45) и информационном ресурсе «List of Prokaryotic names with Standing in Nomenclature» (46), двух источниках, содержащих последние обновления номенклатуры бактерий, на которые ссылается бактериологический кодекс (47).
2. История изменений номенклатуры Erwinia rhapontici
|
Название |
Авторы |
1 Год |
Ссылка |
|
Phytomonas rhapontica Millard 1924 |
W.A. Millard |
1924 |
(48) |
|
Aplanobacter rhaponticum (Millard 1924) White 1936 |
H.L. White |
1936 |
(44) |
|
Bacterium rhaponticum Millard 1924 |
G. Metcalfe |
1940 |
(49) |
|
Xanthomonas rhapontica (Millard 1924) Savulescu 1947 |
T. Savulescu |
1947 |
(50) |
|
Erwinia rhapontici (Millard 2024) Burkholder 1948 |
W.H. Burkholder |
1948 |
(51) |
|
Pseudobacterium rhaponticum (Millard 1924) Krasil'nikov 1949 |
N.A. Krasil'nikov |
1949 |
(52) |
|
Pectobacterium rhapontici (Millard 1924) Patel and Kulkarni 1951 |
M.K. Patel, Y.S. Kulkarni |
1951 |
(53) |
|
Erwinia rhapontici (Millard 1924) Burkholder 1948 |
D.H. Bergey с соавт. |
1957 |
(54) |
|
Erwinia carotovora var. rhapontici (Millard 1924) Dye 1969 |
D.W. Dye |
1969 |
(55) |
|
Erwinia rhapontici (Millard 1924) Burkholder 1948 |
G.J. Buddingh |
1975 |
(56) |
|
G.M. Garrity с соавт. |
2007 |
(45) |
В соответствии с современной классификацией (57), вид E. rhapontici принадлежит роду Erwinia , семейству Erwiniaceae , порядку Enterobacterales , классу Gammaproteobacteria , типу Pseudomonadota , царству Pseudomonadati , домену Bacteria (46).
Патогенные свойства. Возбудитель вызывает два основных вида заболеваний растений: розовый бактериоз зерна (16, 18, 62) и различные виды гнилей, сухой некроз, галлы, увядание, пятнистости и др. (22, 23, 49).
Розовый цвет зерна при заражении E. rhapontici обусловлен выработкой водорастворимого пигмента ферророзамина А, сопровождаемой хелатированием железа (58). То есть бактериоз характеризуется развитием дефицита железа в растениях (59). Способность к хелатированию железа позволяет E. rhapontici конкурировать с другими бактериями, что было показано в опытах in vitro на примере подавления роста E. amylovora (60). Инфекция семян E. rhapontici приводит к снижению всхожести, энергии прорастания, размера семян и, как следствие, к снижению урожая, по некоторым данным на 44 % (61). Существенно ухудшается товарный вид зерна и продуктов его переработки за счет розовой окраски (62).
Одна из важнейших особенностей E. rhapontici — отсутствие специфичности к растению-хозяину, что подтверждается широким перечнем поражаемых растений (табл. 3) и результатами полевых и лабораторных экспериментов (17, 63, 64). Патогенность бактерии обусловлена наличием системы секреции II типа, который отвечает за внеклеточный транспорт целлюлаз и пектиназ у Erwinia spp., вызывающих мягкую гниль, например у E. carotovora и E. chrysanthemi (65). По признаку проявления патогенности E. rhapontici ранее была отнесена к группе carotovora вместе с E. carotovora и E. chrysanthemi, но изучение последовательностей 16S рДНК типовых штаммов бактерий рода Erwinia и ДНК-ДНК гибридизация показали, что E. rhapontici имеет большее сходство с E. persicinus, E. amylovora и E. cypripedii (66). E. rhapontici от большинства других фитопатогенных бактерий рода Erwinia отличает то, что ее вирулентность предположительно не связана с ацилгомосерин лактон (AHL)-опосредованной системой чувства кворума (quorum-sen- sing systems) (67).
-
3. Случаи обнаружений Erwinia rhapontici в разных странах
Страна (регион)
| Растение
Год
Ссылка
С и м п Канада
томы розового бактериоза зерна Triticum aestivum L., Lolium sp.
1937
(98)
Канада (Онтарио)
Triticum aestivum L.
1958
(68)
Канада (Альберта)
Phaseolus vulgaris L.
2007
(17)
Канада (Манитоба)
Phaseolus vulgaris L., Pisum sativum L.
2007
(17)
Канада (Саскачеван)
Cicer arietinum L., Lens culinaris Medik.,
2007
(17)
Pisum sativum L., Triticum aestivum L.
Канада (Альберта, г. Боу-Айленд) Brassica napus L.
2006
(17)
США (Монтана)
Pisum sativum L.
2002
(18)
США (Северная Дакота)
Triticum durum Desf .
1984
(62)
США (Небраска)
Pisum sativum L.
Pisum sativum L.
2008
2016
(69)
(70)
США (Айдахо)
Triticum aestivum L.
1990
(71)
Китай (Ганьсу)
Medicago sativa L.
2018
(72)
Бельгия
Triticum aestivum L.
1990
(15)
Франция
Triticum aestivum L.
1967
(98)
Великобритания
Triticum aestivum L.
1974
(16)
Франция
Triticum aestivum L.
1974
(16)
Симптомы гнилей, некрозов и др.
Мексика (Чапинго) Amaranthus hybridus L.
1990
(73)
Мексика (Мехико)
Spathiphyllum chopin (в ориг. ст. Cuna de moisas var.
2016
(23)
Япония
chopan )
Eutrema wasabi Maxim.
1986
(74)
Литва
Hippeastrum sp., Dianthus sp.
1995
(75)
Россия
Gerbera jamesonii Bolus ex Hook. f.
1987
(76)
Великобритания (посадочный
Hyacinthus orientalis L.
1978
(63)
материал из Нидерландов)
Бывш. Чехословакия (посадоч-
Hyacinthus orientalis L.
1992
(77)
ный материал из Нидерландов) Австрия (Каринтия)
Pyrus L.
2012
(78)
Германия
Pyrus L.
2012
(78)
Южная Корея (Канвондо, г.
Pyrus pyrifolia (Burm.f.) Nakai
2012
(79)
Чхунчхон)
Китай (Сычуань)
Actinidia chinensis Planch.
2017
(20)
Япония (Тохоку)
Allium cepa L.
2019
(80)
Франция
Mentha x piperita L., Melissa officinalis L., Chamaemelum
1992
(81)
Финляндия
nobile (L.) All.
Daucus carota L.
2012
(21)
Венгрия (г. Будакези)
Prunus persica (L.) Batsch
2019
(82)
Великобритания (г. Лидс)
Rheum rhaponticum L.
1924
(44)
Великобритания
Rheum rhaponticum L.
1936
(44)
Великобритания (Йоркшир)
Rheum rhaponticum L.
1940
(49)
Канада (Альберта)
Rheum rhaponticum L.
1976
(83)
Иран (Тегеран)
Beta vulgaris L.
1993
(84)
Китай (Хэбэй)
Apium graveolens var. dulce
2022
(22)
Украина
Lycopersicon lycopersicum L.
1991
(85)
Италия (Сардиния)
Cyclamen persicum var. giganteum
1993
(86)
Южная Корея
Allium sativum L.
1989
(87)
Южная Корея (г. Сувон)
Morus L.
1990
(82)
Израиль
Trifolium Tourn. ex L.
1955
(89)
Китай (Хубэй)
Cymbidium faberi Rolfe.
2010
(90)
Турция (Восточная Анатолия)
Malus P. Mill., Pyrus L., Pyrus pyrifolia (Burm.f.)
2005
(19)
Канада (Британская Колумбия)
Nakai, Cydonia oblonga Mill., Mespilus germanica L., Eriobotrya japonica (Thunb.) Lindl.
Vaccinium corymbosum L.
2019
(91)
Симптомы заболеваний отсутствовали
Мексика (Морелос) Agave atrovensis Karw. ex Salm-Dyck, A. americana L.
2008
(92)
Япония
Rosa rugosa Thunb .
2002
(93)
Япония (Дзёэцу)
Brassica rapa ssp . pekinensis (Lour.) Hanelt
1985
(94)
Россия
Rosa L . (роза)
2020
(95)
Россия (Республика Крым)
Hordeum vulgare L.
2023
(96)
Россия (г. Саратов)
Secale cereal L.
2022
(97)
Примечание. Указано латинское название из цитирующей статьи (98), в которой английское и латинское названия не соответствуют друг другу.
Случаи обнаружения и ареал. E. rhapontici обнаруживали в
Америке, Азии, Европе и Океании (табл. 3), как минимум в 21 стране, а перечень растений-хозяев насчитывает по крайней мере 42 вида, принадлежащих 20 ботаническим семействам — Actinidiaceae , Araceae , Amaranthaceae , Amaryllidaceae , Apiaceae , Asparagaceae , Asteraceae , Brassicaceae , Caryophyl-laceae , Ericaceae , Fabaceae , Lamiaceae , Moraceae , Poaceae , Polygonaceae , Prim-ulaceae , Orchidaceae , Rosaceae , Rutaceae , Solanaceae . В России отмечено только четыре случая выявления E. rhapontici. Из-за отсутствия должных исследований невозможно судить, насколько эта бактерия распространена по регионам и по всей стране в целом.
Способы передачи и распространения. Основным путем распространения E. rhapontici служат семена зерновых и зернобобовых культур (98, 99). Бактерия может сохранять жизнеспособность в семенах в течение длительного периода времени. Это было показано в 2015 году, когда E. rhapontici выделили из семян люцерны, хранившихся при температуре 5 ° C и влажности 55 % как минимум 12 лет (71). Бактерия сохраняется в почве (17), в зараженных растительных остатках и семенах, находящихся на поверхности почвы и на глубине 6 см, выживает в зимний период и заражает растения в следующий цикл вегетации (99).
Повреждение растений ветром, градом или насекомыми на стадии формирования семян имеет решающее значение для того, чтобы E. rhapontici проникла в растение и вызвала розовый бактериоз зерна (63), характеризуя бактерию как условно-патогенный организм (16). G. Metcalfe (49) определял E. rhapontici как «раневой» фитопатоген ревеня. J. Luisetti и F. Rapilly (73) отмечали, что довольно серьезная вспышка розового бактериоза зерна пшеницы во Франции в 1966 году совпала с нашествием галлиц (Diptera, Cecidomyiidae), личинки которых повреждают растения в процессе питания (100).
Морфологические и биохимические свойства. Бактерия грамотрицательная, факультативно анаэробная, подвижная, имеет форму палочки размером 0,3-0,8х0,5-1,5 мкм, с 3-7 перитрихиальными жгутиками (18, 56, 93). Многие исследования, посвященные E. rhapontici , дают характеристику ее ферментному составу, описывают способы культивирования и использование в производстве некоторых биологически активных веществ. Бактерия восстанавливает нитраты до нитритов, тест на каталазу положительный (93, 101), не производит индол (93). В тесте на яичный желток показатели оксидазы, уреазы и лецитиназы отрицательны (101); декарбоксилазы на аргинин, лизин, оринтин и глутаминовую кислоту по методу Меллера не обнаружены, а ДНКаза и фенилаланиндезаминаза не вырабатываются; образование фосфатазы и получение редуцирующих веществ из глюконата и из сахарозы варьирует; сероводород образуется из цистеина; большинство штаммов продуцируют ацетоин, но реакция с метиловым красным неопределенна или вариабельна (101).
Для роста E. rhapontici необходимы органические соединения азота. Из различных сахаров образуется кислота с видимым выделением газа или без него (56). Показаны различия у штаммов E. rhapontici в кислотах, производимых в процессе расщепления углеводов (16). Более 80 % штаммов способны к гидролизу арабинозы, рибозы, глюкозы, галактозы, маннозы, фруктозы, рамнозы, сахарозы, целлибиозы, мелибиозы, лактозы, мальтозы, раффинозы, глицерина, маннита, сорбита, инозита, салицина, эскулина и р-метилглюкозида, при этом менее 20 % штаммов гидролизуют адонит и декс- трин, способность к гидролизу ксилозы, мелезитозы, а-метилглюкозида и дульцитола варьирует в зависимости от штамма, а казеин, крахмал и целлюлозу не гидролизует (63, 93). В то же время R. Riekki с соавт. (65) в 2000 году показали, что все изученные ими изоляты E. rhapontici содержали ген celA или его гомолог, ответственные за выработку разрушающего целлюлозу фермента целлюлазы.
Бактерия способна к образованию кислоты из этанола и салицина, не использует в метаболизме галловую, протокатеховую, 4-гидроксибензойную, 3,4-дигидроксикоричную, салициловую, хлорогеновую и дубильную кислоты (93). При этом E. rhapontici проявляет повышенную устойчивость к некоторым из перечисленных кислот. Например, при изучении антимикробной активности экстракта физалиса перуанского ( Physalis peruviana ), богатого галловой кислотой, для ингибирования роста E. rhapontici потребовалась концентрация экстракта в 2 раза больше, чем для вторых по устойчивости тестируемых бактерий ( Bacillus subtilis , Escherichia coll', Pseudomonas aeruginosa ), и в 8 раз больше, чем для самого чувствительного вида — Pseudomonas syringae (102).
-
E. rhapontici растет в бульоне с триптофаном, в молоке, в растворе KOH и в цитратном растворе, а также в 5 % растворе NaCl и в бульонах KCN (49, 63, 93).
Более 80 % штаммов используют в качестве источников углерода и энергии формиат, ацетат, цитрат, лактат, малат, глюконат, сукцинат, фумарат и малонат, менее 20 % — оксалат, пропионат и бензоат; использование тартрата и галактуруната варьирует в зависимости от штамма. При этом аспарагин может быть использован в качестве единственного источника углерода и азота (63). Недавние исследования M. Sinn с соавт. (103, 104) показывают, что в качестве источника азота бактерией также может использовать гуанидин.
-
E. rhapontici образует шарообразные колонии в столбике питательного желатина, но сам субстрат не разжижает (49). При рН 7,0 бактерия не демонстрирует пектолитических свойств, но > 80 % штаммов вызывают слабое гниение на ломтиках картофеля и лука, а некоторые и на ломтиках огурца (63).
-
E. rhapontici обладает важной способностью к выработке фермента сахарозоизомеразы, используемого для производства заменителей сахара — изомальтулозы и трегалулозы (105, 106). Биоконверсия сахарозы в менее доступную форму, изомальтулозу, крайне важна для E. rhapontici , поскольку позволяет ей успешно конкурировать с другими организмами за источник углерода и энергии (63). Помимо производства заменителей сахара, E. rhapontici используется в качестве агента биосинтеза а -арбутина, одного из компонентов косметических средств (107).
В исследовании, посвященном компонентному составу бактерий, участвующих в ферментации традиционного мексиканского алкогольного напитка пульке (pulque) из сока агавы, E. rhapontici была обнаружена в качестве одного из самых распространенных видов (92).
В 2023 году T. Kaur с соавт. (108) опубликовали результаты исследования, в котором выделили штамм E. rhapontici с мощными азотофиксирующими свойствами на пальчатом просо ( Eleusine coracana ).
На инфузионном агаре бактерия образует круглые, выпуклые, гладкие, блестящие, полупрозрачные колонии с ровными краями, которые достигают 2-3 мм в диаметре за 48 ч при температуре 25 °C. На ревеневом агаре колонии немного крупнее, часто с желтоватым оттенком (49). На питательном агаре через 3 сут при 27 °C колонии E. rhapontici имеют следующий вид: беловатые, гладкие, круглые или слегка неправильной формы, приподнятые или слабо выпуклые, часто с более плотным центром, маслянистые, полупрозрачные или непрозрачные, блестящие, диаметром 12 мм. При той же температуре на 5 % сахарозном питательном агаре колонии становятся слизистыми по краям, с более плотной сердцевиной, а на сахарозо-пептонном агаре через 3 сут — слизистыми до полужидкого состояния (101).
Некоторые штаммы E. rhapontici продуцируют розовый водорастворимый диффузионный пигмент на средах, содержащих D-глюкозу, сахарозу или глицерин (63, 93) (рис.).
Колонии Erwinia rhapontici VNIIKR-B-0065 на Левановой среде с добавлением цитрата железа (0,05 г/л) и аспарагина (10 г/л) после 7 сут инкубирования при 27 ° C (фото И.С. Авдеева).
Оптимальная температура роста бактерии составляет, по разным источникам, 25-30 ° C (63, 93). Этот показатель зависит, по всей видимости, от штамма. Большинство штаммов могут расти при 36 ° C, а некоторые и при более высокой температуре (63). Оптимальное значение pH для E. rhapontici составляет 6,0-7,0 (93).
Серия исследований позволила изучить антимикробную эффективность различных противомикробных веществ против фитопатогена. E. rhapontici демонстрирует чувствительность к эритромицину (98), стрептомицину, неомицину, меропенему, энрофлоксацину, цефоперазону, цефтазидиму, ципрофлоксацину, гентамицину (109) и маслу орегано ( Origanum vulgare ) (110). J. Wilson с соавт. (111) в 2023 году выявить в бактерии Bacillus velezensis новые ди- и трипептиды, состоящие из L-аланина и C-концевого L-фосфоноаланина (фосфоноаламиды E и F), показавшие высокую антибактериальную активность в отношении E. rhapontici и некоторых других фитопатогенов. Обнаружена высокая устойчивость бактерии к амоксициллину, бацитрацину, ампициллину, касугамицину, пенициллину G+, амикацину, тетрациклину и тилозину (109).
Методы выявления и идентификации. В исследуемой литературе отсутствуют сведения о целенаправленном обследовании растительных насаждений с целью обнаружения E. rhapontici. Находки патогена, как правило, сделаны вследствие анализа растений с признаками бактериозов. В то же время в связи с экспортными требованиями к отсутствию бактерии 46
в растительной продукции требуются методы обследований площадей под зерновыми культурами и отбора образцов. С этой целью может быть использован метод, при котором с каждого поля, отбирают по 5-15 стеблей, срезанных у первого междоузлия, или 15 проростков (112). Образцы необходимо упаковать таким образом, чтобы предотвратить контаминацию и повреждения, переложив растительный материал бумагой или салфетками, и хранить до проведения исследований при 2-8 ° C (70, 113).
В большинстве публикаций, содержащих описание подготовки проб растений и семян для анализа, упоминается поверхностная стерилизация анализируемого материала с помощью 70-75 % этанола и последующего промывания стерильной дистиллированной водой (20, 69, 114). При стерилизации материала для последующей прямой изоляции бактерий пораженные ткани срезают, промывают водой, подсушивают полотенцами, погружают в этанол на 3 с и кратковременно обжигают (70). Для последующей подготовки проб посредством экстракции или смыва материал отбирают на границе больной и здоровой ткани (20, 113). Смыв проводят с использованием стерильной воды (20), а для экстракции применяют фосфатно-солевой буфер или 0,9 % физиологический раствор (22, 112, 113). Полученный экстракт или смыв может быть подвергнут центрифугированию для повышения концентрации бактерий в пробе (96, 112, 113).
Для подготовки проб семян зерновых и зернобобовых культур используют метод, основанный на размягчении семян посредством замачивания в солевом буфере, раздрабливании и концентрировании бактериальных клеток с помощью высокоскоростного центрифугирования (115-117). Для изоляции и культивирования E. rhapontici используют различные, в том числе готовые, питательные среды, такие как среда Кинга Б, LB агар (Luria-Bertani), дрожжевой пептон, картофельный пептонно-глюкозный агар, картофельный декстрозный агар, дрожжевая декстрозная карбонатная среда, казаминовый пептонно-глюкозный агар (20, 22, 74), DSMZ Medium 1a, CIP Medium 3, Колумбийский агар (118), питательный агар с дрожжевым экстрактом (NBY) (18), пептонно-дрожжевой агар (69), триптон-соевый агар (TSA) и сахарозо-пептонный агар (SPA) (43, 70). Следует учитывать морфологические различия колоний возбудителя, выделенного на разных питательных средах. Выделение розового пигмента среди множества видов бактерий встречается нечасто, что может облегчить задачу в идентификации, но некоторые штаммы E. rhapontici не выделяют его ни при каких условиях среды (22).
Характеристика бактериальных культур может быть проведена с использованием классических биохимических тестов и коммерческих тест-систем — API 50CHE и системы MIDI (69, 97). Примером классического теста служит пестрый ряд Гисса, который позволяет выявить сахаролитические свойства штаммов (119). Высокая степень вариабельности биохимических признаков изолятов E. rhapontici делает ее крайне сложным объектом в идентификации (84), повышая актуальность разработки и применения молекулярных методов идентификации бактерии.
В мировой практике для идентификации E. rhapontici успешно применяют амплификацию последовательностей различных участков генома с последующим секвенированием (22, 70, 96), а также видоспецифичные тесты (табл. 4).
-
4. Праймеры, используемые для молекулярно-генетической идентификации Erwinia rhapontici
Праймер
Последовательность 5' ^ 3'
Ген
Ссылка
Комбинация праймеров
Праймеры для амплификации универсальных участков бактериального генома
27F
1492R
AGAGTTTGATCMTGGCTCAG
GGTTACCTTGTTACGACTT
16S-23S рРНК
(120)
27F/1492R
27F-YM
907R
AGAGTTTGATYMTGGCTCAG
CCGTCAATTCMTTTGAGTTT
(121)
(122)
27F-YM/907R
G1
L1
GAAGTCGTAACAAGG
CAAGGCATCCACCGT
16S-23S рДНК
(21)
G1/L1
Eu530F
EU1449R
TGACTGGAGTGCCAGCAGCCGCGG
TGACTGACTGAGGCTACCTTGTTACGACTT
(92)
Eu530F/Eu1449R
Праймеры для амплифика «домашнего хо
ции участков генов з я й с т в а»
acnA3F
acnA3R
CMAGRGTRTTRATGCARGAYTTTAC GATCATGGTGGTRTGSGARTCVGT
acnA
(114)
acnA3F/acnA3R
gapA326F ATCTTCCTGACCGACGAAACTGC
gapA845R ACGTCATCTTCGGTGTAACCCAG
gapA
gapA326F/gapA845R
icdA400F
icdA977R
GGTGGTATCCGTTCTCTGAACG
TAGTCGCCGTTCAGGTTCATACA
icdA
icdA400F/icdA977R
mdh86F mdh628R
CCCAGCTTCCTTCAGGTTCAGA
CTGCATTCTGAATACGTTTGGTCA
mdh
mdh86F/mdh628R
mtlD146F mtlD650R mtIDF mltDR
GGCCGGTAATATCGGCCGTGG CATTCGCTGAAGGTTTCCACCGT CTGYTGGATGCICTSAACMGYCG TCCACRGCRGAATCWACRAATCC
mtlD
mtlD146F/mtlD650R
mtIDF/mltDR
pgi815F pgi1396R pgiF2 pgiR2 pgiF pgiR
TGGGTCGGCGGCCGTTACTC TGCCTTCGAATACTTTGAACGGC CTGTCYACCAATGCSAAAGCCG CAGCAGGATGGAGTTGGTCGG TCTYTIGGITTTGAKAAYTTTGA YGCCGCYGIAAATTCIGCTTC
pgi
pgi815F/pgi1396R
pgiF2/pgiR2
pgiF/pgiF
proAF1
proAR1
CGGYAATGCGGTGATTCTGCG
GGGTACTGACCGCCACTTC
proA
proAF1/proAR1
recA1
recA2
GGTAAAGGGTCTATCATGCG
CCTTCACCATACATAATTTGGA
recA
(123)
recA1/recA2
gyrA1 gyrA4
TGGTGACGCGTCGTACCATT
GCAGAGAACAGCATCGCTTC
gyrA
gyrA1/gyrA4
rpoS1 rpoS2
ATGAGCCAAAGTACGCTGAA ACCTGAATCTGACGAACACG
Праймеры для п видоспецифичных
rpoS
роведения ПЦР-тестов
rpoS1/rpoS2
TSU01
TSU02
CCCTGAAGCCATCACTTATT
AACACACAGCTTCAGGATG
rpoD
(74)
TSU01/TSU02
isoRF
isoRR
CCTGCAGTGCCGGGCCAGAT
AGTGTGACTGTTGTTTTTCAG
NX-5
(79)
isoRF/isoRR
recA_8
recA 8c
TTGGGCGTGGATATCGAC
CACTTTAACGCGGGTCTCA
RecA
(79)
recA_8/recA_8c
gpd_8
gpd 8c
GGGATGCAGTAAGCGTC
CTTCAACGATACCGAAGTC
gpd
gpd_8/gpd_8c
ERH-1A
ERH-1B
AGTGGCGGTCCTGGTAAAAG
AAGCATCTCCCAGCCAAGTC
ampC
(124)
ERH-1A/ERH-1B
В то же время в литературе отсутствуют публикации с описанием тестов ПЦР в режиме реального времени (ПЦР-РВ/Real-time PCR) и каких-либо других диагностических экспресс-методов.
Для идентификации E. rhapontici с высокой степенью достоверности может быть использован метод MALDI-TOF MS (Matrix-Assisted Laser Desorption/Ionization—Time-of-Flight Mass Spectrometry) (82), основанный на времяпролетной масс-спектрометрии с матрично-активированной лазерной десорбцией-ионизацией (125). Отметим, что для эффективного применения MALDI-TOF MS требуется наличие в библиотеке прибора максимально возможного числа белковых профилей искомой бактерии.
Таким образом, анализ научных публикаций показывает, что патогенные свойства Erwinia rhapontici проявляются на растениях как минимум 20 ботанических семейств. Фитопатоген широко распространен в странах мира, при этом было только четыре случая его выявления на территории Российской Федерации. В то же время бактерия может нанести существенный ущерб урожаю сельскохозяйственных культур и стать причиной ограничения экспорта российского зерна. Штаммы E. rhapontici обладают высокой степенью вариабельности биохимических признаков, что делает классические тесты малопригодными для идентификации бактерии при отсутствии иных диагностических методов. Кроме того, для регулирования фитопатогена как вида, значимого для экспорта, необходимы экспресс-методы диагностики. Дальнейшие исследования, на наш взгляд, должны включать разработку тестов ПЦР-РВ как для тестирования чистых бактериальных культур, так и анализа растительных экстрактов. Это будет возможно только при наличии большого числа штаммов E. rhapontici и их полногеномных последовательностей. Особенно важен для указанной цели поиск штаммов российского происхождения, преимущественно с зерновых культур, поскольку экспресс-методы анализа будут применяться при проверке экспортируемого Россией зерна. Выделенные штаммы должны быть включены в библиотеку MALDI, чтобы в будущем обеспечить еще большую достоверность идентификации. Другим перспективным направлением служит разработка селективной питательной среды, которая позволит ускорить процесс изоляции новых штаммов E. rhapontici. Эта задача может быть выполнена с использованием представленных в настоящей работе сведений о чувствительности и толерантности бактерии к различным противомикробным веществам.
1 ФГБУ Бсероссийский центр карантина растений, 140150 Россия, Московская обл., м.о. Раменский, пгт. Быково, ул. Пограничная, 32,


